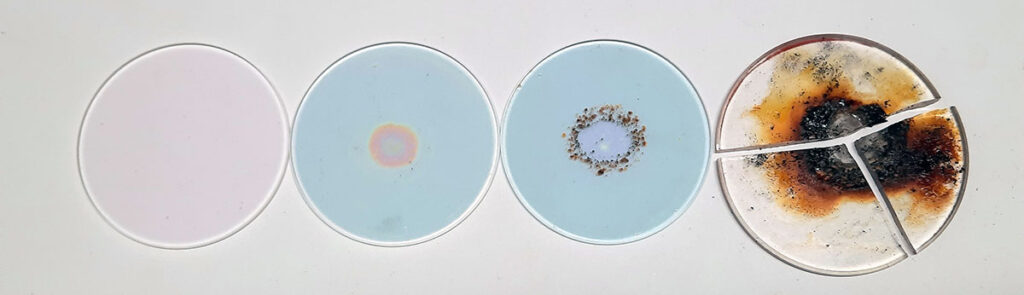
Condition of laser cleaning head protective glass – clean, dirty, damaged, and broken

Laserest OÜ provides maintenance and repair services for laser cleaning machines!
More than 7 years of practical experience in laser cleaning technology shows that regular maintenance is the best way to prevent failures and ensure long-term reliability of the equipment.

Laser Cleaning Equipment Maintenance
Just like any other work equipment, laser cleaning machines require regular maintenance to preserve their reliability, performance, and safety.
Laserest OÜ has over 7 years of hands-on experience with laser cleaning technology, and our experience clearly shows: consistent maintenance is the best way to prevent costly repairs and ensure long-term operational stability.
Regular maintenance ensures:
-
Maximum cleaning performance of the equipment
-
Longer lifespan and reduced risk of malfunctions
-
Lower maintenance and operating costs in the long run
Daily maintenance: Protective glass and laser head
The protective glass of the laser cleaning head is one of the most important yet vulnerable optical components.
Its cleanliness directly affects the quality of the laser beam, output power, and operating temperature of the head.
Inspect the protective glass before each workday.
If it is dirty, clean it with a suitable alcohol-free cleaning cloth or replace it if necessary.
A damaged or heavily contaminated protective glass absorbs part of the laser beam’s energy, raising the head temperature and potentially causing system failures.
Daily maintenance tasks:
-
Visual inspection of the machine and cables before operation
-
Cleaning or replacing the laser head protective glass
-
Checking the cable and connectors
Weekly maintenance: Surfaces and filters
In working environments with high dust or metal oxide levels, dirt accumulates on the equipment surfaces, filters, and ventilation openings.
Recommended weekly actions:
-
Clean the exterior surfaces of the equipment and laser head cable
-
Inspect and, if needed, clean the ventilation and filter system
-
Check the freedom of movement of the laser head and the tightness of connections
Quarterly maintenance: Cooling and ventilation system
The cooling system of a laser cleaning device is critical — overheating may lead to permanent laser damage.
For air-cooled units:
-
Dust and dirt accumulate in the ventilation openings and on the fan blades.
-
Once per quarter, clean the fans, housing vents, and interior with compressed air or a vacuum cleaner.

Laser cleaning machine cooling vents – dusty and cleaned If you operate in a very dusty environment, clean the filters more frequently!!!
For liquid-cooled units:
-
Check the coolant level and quality before daily use.
-
Clean the cooling radiator and check the fluid circulation for leaks.
Signs that maintenance is required
If you notice any of the following, it’s time to perform maintenance:
-
The laser no longer reaches its usual power output
-
The laser head or device heats up faster than normal
-
The fans are louder than usual
Our recommendation
Based on our experience, it’s clear: regular maintenance extends the lifespan of your laser cleaning machine several times over.
We recommend creating a simple maintenance schedule (daily, weekly, quarterly) and following both the manufacturer’s instructions and Laserest OÜ personal recommendations.
If you need help with maintenance, spare parts (such as protective glasses, filters, or coolant), or equipment inspection — contact us.
We’ll help ensure that your laser cleaning equipment continues to operate efficiently for years to come.